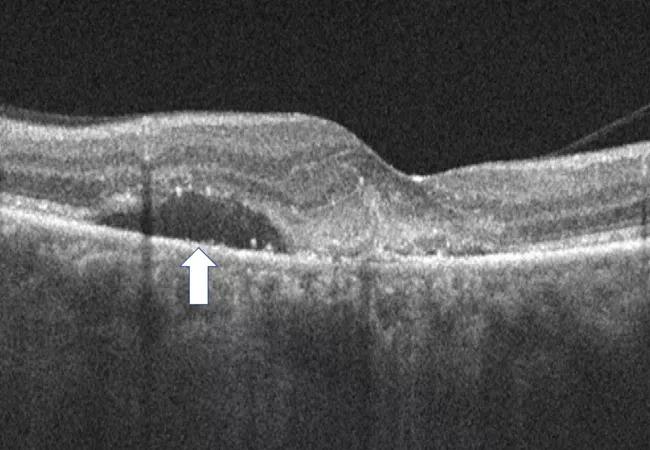

Advanced OCT features may help individualize treatment intervals
Image content: This image is available to view online.
View image online (https://assets.clevelandclinic.org/transform/816ed9be-b8b4-4bc9-8764-eb644c6026a9/22-EYE-3438365-CQD-Fluid-volatility-in-nAMD-Ehlers_jpg)
22-EYE-3438365 CQD-Fluid volatility in nAMD-Ehlers
The impact of subretinal fluid on overall outcomes in neovascular AMD (nAMD) has been controversial. Multiple studies have demonstrated that the very presence of subretinal fluid may not have a negative impact on overall visual acuity. In some cases it may be associated with better overall visual acuity. However, recent studies have shown that overall fluctuation in retinal thickness may have negative implications. This generates new and important questions related to the specific types of fluid that are causing the fluctuations in retinal thickness and their impact on anatomy and visual outcomes.
Advertisement
Cleveland Clinic is a non-profit academic medical center. Advertising on our site helps support our mission. We do not endorse non-Cleveland Clinic products or services. Policy
In a recent post hoc analysis of the OSPREY study, led by Justis P. Ehlers, MD, of Cleveland Clinic Cole Eye Institute, subretinal fluid stability (i.e., lack of fluctuation whether fluid is absent or present) in nAMD appears to be associated with better overall anatomic and functional response to anti-vascular endothelial growth factor (VEGF) therapy. Greater fluid volatility may signal the need for more aggressive treatment due to risk for progressive ellipsoid zone (i.e., photoreceptor) loss and increased subretinal fibrosis.
Anti-VEGF therapy, via regular intravitreal injections, is the current standard of care for patients with nAMD. Improvement in visual acuity is often associated with decreased retinal fluid and retinal thickness as measured by optical coherence tomography (OCT). However, the link between fluid and vision has not always been clear. Until recently, limitations in technology did not allow for trials to quantify fluid in a volumetric fashion. In addition, not all patients respond to therapy, and the optimal treatment interval for a given patient isn’t always apparent.
In the new analysis of 81 eyes with nAMD treated with anti-VEGF, lower volatility of subretinal fluid volume as seen on OCT was associated with decreased subretinal hyperreflective material (i.e., subretinal fibrosis) and greater improvement in total ellipsoid zone attenuation (i.e., improving photoreceptor/ellipsoid zone integrity).
These findings may have major implications for nAMD disease management, particularly in regard to individualizing anti-VEGF treatment intervals, says Dr. Ehlers.
Advertisement
“We want to be sure that we have optimized the treatment regimen for every patient,” he says. “The general goal is often to treat to complete fluid resolution, but not all patients will achieve this goal. These findings have led me to focus on being sure that whatever fluid level I’m tolerating, particularly subretinal fluid, is not fluctuating during treatment and is truly static.”
This suggests caution, since retina specialists have generally become more tolerant of subretinal fluid, he notes.
“Dynamic subretinal fluid is probably damaging to the outer retina,” says Dr. Ehlers. “I think this may suggest that we should be doing earlier surveillance with OCT in some of these patients to make sure that we have it under optimal control prior to being too aggressive about extension.”
If the fluid is fluctuating, the treatment interval may need to be shortened.
“We often try to stretch out the visits as far as possible while maintaining the gains that we’ve had; as an example, we might go to every 12 weeks,” he says. “But, if we find that the subretinal fluid is increasing a little bit, we’re probably waiting too long, so we might go to only 10 weeks. These findings offer some unique insights into the complexity of nAMD management and the potential critical facets involved in truly individualizing therapy.”
Data were taken from the phase 2 OSPREY study that investigated the anti-VEGF agent brolucizumab and aflibercept in nAMD. The analysis was performed using a machine learning-enhanced multilayer segmentation and feature-analysis platform for OCT that was developed at Cleveland Clinic. This platform enabled volumetric assessment of multiple exudative parameters and outer retinal integrity. Retinal volatility was quantified as the standard deviation across weeks 12 to 56 for six OCT metrics: central subfield thickness, total fluid volume, subretinal fluid volume, intraretinal fluid volume, total macular total retinal fluid index and central macular total retinal fluid index.
Advertisement
For each OCT measure, eyes with the top quartile of volatility (“high volatility”) were compared with the bottom quartile (“low volatility”).
During weeks 12-56 (maintenance phase), high-volatility eyes showed a significantly increased volume of subretinal hyperreflective material (i.e., subretinal fibrosis) compared to low-volatility eyes (P = .027). Compared to low-volatility eyes, those with high volatility in central subfield thickness, total fluid and subretinal fluid showed significantly less improvement in total ellipsoid zone attenuation during the maintenance phase (P < .001, P = .033 and P = .043, respectively).
Moreover, exudative instability during weeks 4-8 or weeks 8-12 in multiple OCT parameters was associated with greater volatility during the maintenance phase (P < .05).
Although the largest improvements in best-corrected visual acuity (BCVA) with anti-VEGF treatment in nAMD typically occur within the first 12 weeks of treatment, in this analysis eyes with low volatility showed further improvement in BCVA beyond week 12, while no such gains were seen in the high-volatility groups.
Dr. Ehlers’ team at the Cole Eye Institute recently completed a larger validation of these findings from a phase 3 clinical trial that they plan to publish soon. Meanwhile, eye care specialists can use the findings now.
“A patient may say that they’re tired of anti-VEGF injections, and you may determine that the patient may not need additional treatment because of their imaging and clinical findings,” says Dr. Ehlers. “But undertreatment is a leading cause of vision loss. Our research reinforces the importance of minimizing fluid volatility and maintaining maximal stability of the disease activity to hopefully provide the best outcomes for patients.”
Advertisement
Advertisement
Early data shows risk is 73% higher in patients with lupus, 40% higher in patients with rheumatoid arthritis
Identifies weak spots in the cornea before shape change occurs
Study highlights the value of quantitative ultra-widefield angiography
Switching medications may decrease treatment burden and macular fluid
Interventions abound for active and stable phases of TED
Corneal imaging and interpretation play a major role
Cole Eye Institute imaging specialists are equal parts technician, artist and diagnostician
Effect of low-dose atropine and dual-focus contact lenses is unknown in patients with comorbid eye conditions